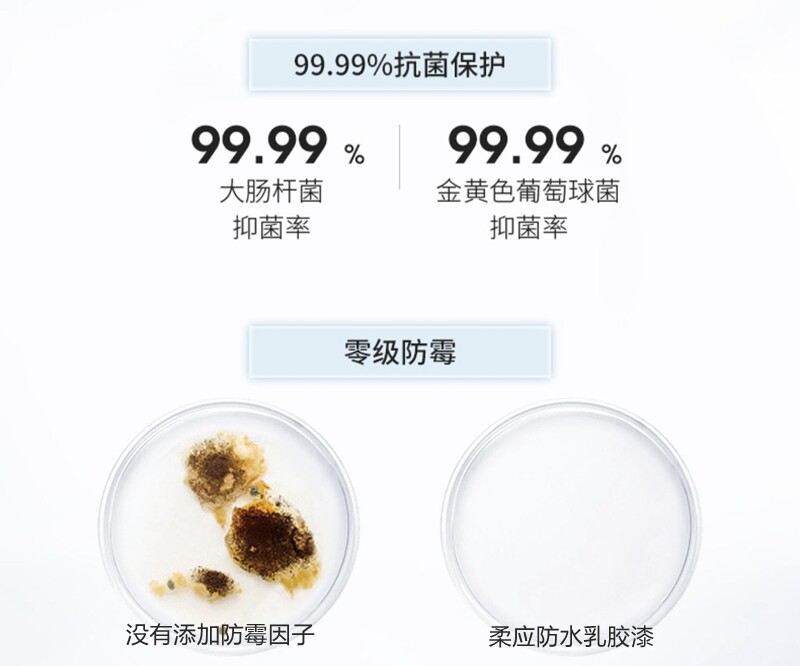

Кухня и ванная комната посвященная латексная краска балконная краска для ванной комнаты кухня туалетная водонепроницаем

Цена: 630-11 766руб. (¥29.8)
Артикул: 567009421688
Вес товара: ~0.7 кг. Указан усредненный вес, который может отличаться от фактического. Не включен в цену, оплачивается при получении.
Описание товараPHA+PGRpdiBzdHlsZT0id2lkdGg6IDc1MC4wcHg7Ij48aW1nIHNyYz0iaHR0cHM6Ly9pbWcuYWxpY2RuLmNvbS9pbWdleHRyYS9pMi8yNzM3MjI4MzI4L08xQ04wMXZEdGZhajJCT0gzNUg1SFRnXyEhMjczNzIyODMyOC5wbmciPjwvZGl2PjxwPjxpbWcgYWxpZ249ImFic21pZGRsZSIgc3JjPSJodHRwczovL2ltZy5hbGljZG4uY29tL2ltZ2V4dHJhL2kxLzI3MzcyMjgzMjgvTzFDTjAxN1E3M2ZZMkJPSDBoSEJlZGZfISEyNzM3MjI4MzI4LmpwZyIgc3R5bGU9Im1heC13aWR0aDogNzUwLjBweDsiPjxpbWcgYWxpZ249ImFic21pZGRsZSIgc3JjPSJodHRwczovL2ltZy5hbGljZG4uY29tL2ltZ2V4dHJhL2kyLzI3MzcyMjgzMjgvTzFDTjAxNDJCdGYyMkJPSDN5ZUZsMWpfISEyNzM3MjI4MzI4LmpwZyIgc3R5bGU9Im1heC13aWR0aDogNzUwLjBweDsiPjxpbWcgYWxpZ249ImFic21pZGRsZSIgc3JjPSJodHRwczovL2ltZy5hbGljZG4uY29tL2ltZ2V4dHJhL2kxLzI3MzcyMjgzMjgvTzFDTjAxRFdhR3R6MkJPSDBkNHVuYjNfISEyNzM3MjI4MzI4LmpwZyIgc3R5bGU9Im1heC13aWR0aDogNzUwLjBweDsiPjxpbWcgYWxpZ249ImFic21pZGRsZSIgc3JjPSJodHRwczovL2ltZy5hbGljZG4uY29tL2ltZ2V4dHJhL2kzLzI3MzcyMjgzMjgvTzFDTjAxNUwxdVBaMkJPSDQ3amx6cTVfISEyNzM3MjI4MzI4LmpwZyIgc3R5bGU9Im1heC13aWR0aDogNzUwLjBweDsiPjxpbWcgYWxpZ249ImFic21pZGRsZSIgc3JjPSJodHRwczovL2ltZy5hbGljZG4uY29tL2ltZ2V4dHJhL2kyLzI3MzcyMjgzMjgvTzFDTjAxc0tkcjBSMkJPSDQzak1TelFfISEyNzM3MjI4MzI4LmpwZyIgc3R5bGU9Im1heC13aWR0aDogNzUwLjBweDsiPjxpbWcgYWxpZ249ImFic21pZGRsZSIgc3JjPSJodHRwczovL2ltZy5hbGljZG4uY29tL2ltZ2V4dHJhL2kxLzI3MzcyMjgzMjgvTzFDTjAxNmVZZXpoMkJPR3ZabW9nS0ZfISEyNzM3MjI4MzI4LmpwZyIgc3R5bGU9Im1heC13aWR0aDogNzUwLjBweDsiPjxpbWcgYWxpZ249ImFic21pZGRsZSIgc3JjPSJodHRwczovL2ltZy5hbGljZG4uY29tL2ltZ2V4dHJhL2kxLzI3MzcyMjgzMjgvTzFDTjAxOUxYRWF0MkJPSDBpeVVRRURfISEyNzM3MjI4MzI4LmpwZyIgc3R5bGU9Im1heC13aWR0aDogNzUwLjBweDsiPjxpbWcgYWxpZ249ImFic21pZGRsZSIgc3JjPSJodHRwczovL2ltZy5hbGljZG4uY29tL2ltZ2V4dHJhL2kyLzI3MzcyMjgzMjgvTzFDTjAxWXVhamxSMkJPSDRCN0JmRTNfISEyNzM3MjI4MzI4LmpwZyIgc3R5bGU9Im1heC13aWR0aDogNzUwLjBweDsiPjxpbWcgYWxpZ249ImFic21pZGRsZSIgc3JjPSJodHRwczovL2ltZy5hbGljZG4uY29tL2ltZ2V4dHJhL2kxLzI3MzcyMjgzMjgvTzFDTjAxTFkwQzQ2MkJPSDBjaE14aTlfISEyNzM3MjI4MzI4LmpwZyIgc3R5bGU9Im1heC13aWR0aDogNzUwLjBweDsiPjxpbWcgYWxpZ249ImFic21pZGRsZSIgc3JjPSJodHRwczovL2ltZy5hbGljZG4uY29tL2ltZ2V4dHJhL2k0LzI3MzcyMjgzMjgvTzFDTjAxNU11czZUMkJPSDQ2dndtdkFfISEyNzM3MjI4MzI4LmpwZyIgc3R5bGU9Im1heC13aWR0aDogNzUwLjBweDsiPjxpbWcgYWxpZ249ImFic21pZGRsZSIgc3JjPSJodHRwczovL2ltZy5hbGljZG4uY29tL2ltZ2V4dHJhL2k0LzI3MzcyMjgzMjgvTzFDTjAxVjNMaE1GMkJPR3hSUGNNSDVfISEyNzM3MjI4MzI4LmpwZyIgc3R5bGU9Im1heC13aWR0aDogNzUwLjBweDsiPjxpbWcgYWxpZ249ImFic21pZGRsZSIgc3JjPSJodHRwczovL2ltZy5hbGljZG4uY29tL2ltZ2V4dHJhL2kxLzI3MzcyMjgzMjgvTzFDTjAxTGR2ZzllMkJPSDQ2YnY0a1JfISEyNzM3MjI4MzI4LmpwZyIgc3R5bGU9Im1heC13aWR0aDogNzUwLjBweDsiPjxpbWcgYWxpZ249ImFic21pZGRsZSIgc3JjPSJodHRwczovL2ltZy5hbGljZG4uY29tL2ltZ2V4dHJhL2kyLzI3MzcyMjgzMjgvTzFDTjAxZ0V0RlQ5MkJPR3ZpVkpiRGJfISEyNzM3MjI4MzI4LmpwZyIgc3R5bGU9Im1heC13aWR0aDogNzUwLjBweDsiPjxpbWcgYWxpZ249ImFic21pZGRsZSIgc3JjPSJodHRwczovL2ltZy5hbGljZG4uY29tL2ltZ2V4dHJhL2kxLzI3MzcyMjgzMjgvTzFDTjAxNTAzNzRQMkJPSDFvek9SbWpfISEyNzM3MjI4MzI4LmpwZyIgc3R5bGU9Im1heC13aWR0aDogNzUwLjBweDsiPjxpbWcgYWxpZ249ImFic21pZGRsZSIgc3JjPSJodHRwczovL2ltZy5hbGljZG4uY29tL2ltZ2V4dHJhL2kxLzI3MzcyMjgzMjgvTzFDTjAxcDZoajR6MkJPSDFvSXFLV0pfISEyNzM3MjI4MzI4LmpwZyIgc3R5bGU9Im1heC13aWR0aDogNzUwLjBweDsiPjxpbWcgYWxpZ249ImFic21pZGRsZSIgc3JjPSJodHRwczovL2ltZy5hbGljZG4uY29tL2ltZ2V4dHJhL2k0LzI3MzcyMjgzMjgvTzFDTjAxaEw0OVFXMkJPR3c1MGI3YkNfISEyNzM3MjI4MzI4LmpwZyIgc3R5bGU9Im1heC13aWR0aDogNzUwLjBweDsiPjxpbWcgYWxpZ249ImFic21pZGRsZSIgc3JjPSJodHRwczovL2ltZy5hbGljZG4uY29tL2ltZ2V4dHJhL2kyLzI3MzcyMjgzMjgvTzFDTjAxMUtsd1BXMkJPR3czdlhHWjVfISEyNzM3MjI4MzI4LnBuZyIgc3R5bGU9Im1heC13aWR0aDogNzUwLjBweDsiPjxpbWcgYWxpZ249ImFic21pZGRsZSIgc3JjPSJodHRwczovL2ltZy5hbGljZG4uY29tL2ltZ2V4dHJhL2k0LzI3MzcyMjgzMjgvTzFDTjAxM0ZaN2hVMkJPR3ZmSGZuYXZfISEyNzM3MjI4MzI4LmpwZyIgc3R5bGU9Im1heC13aWR0aDogNzUwLjBweDsiPjxpbWcgYWxpZ249ImFic21pZGRsZSIgc3JjPSJodHRwczovL2ltZy5hbGljZG4uY29tL2ltZ2V4dHJhL2k0LzI3MzcyMjgzMjgvVEIyNE5GNW9GbVdCdU5qU3NwZFhYYnVnWFhhXyEhMjczNzIyODMyOC5qcGciIHN0eWxlPSJtYXgtd2lkdGg6IDc1MC4wcHg7Ij48L3A+PC9wPg==
Продавец:海阔天空74736005
Рейтинг:

Всего отзывов:0
Положительных:0
Выберите вариацию / цвет




















- Белый, 450 грамм
Выберите размер / комплектацию
- 10L
- 1L
- 5L
- 2L
Добавить в корзину
- Информация о товаре
- Фотографии
| Емкость: | 1L, 2L, 5L, 10L |
| Цвет: | Белый, Светло-серый, Серый, Темно-серый, Лазурный, Светло-фиолетовый, Фиолетовый, Бежевый, Светло-голубой, Розовый, Светло-зеленый, Светло-желтого, Сине-серый, Мятно-зеленый, Лимон, Светло-розовый, Грязный розовый, Светло -серый синий, Яблочно-зеленый, Белый, 450 грамм, Анти -лкали закрытый учебник |